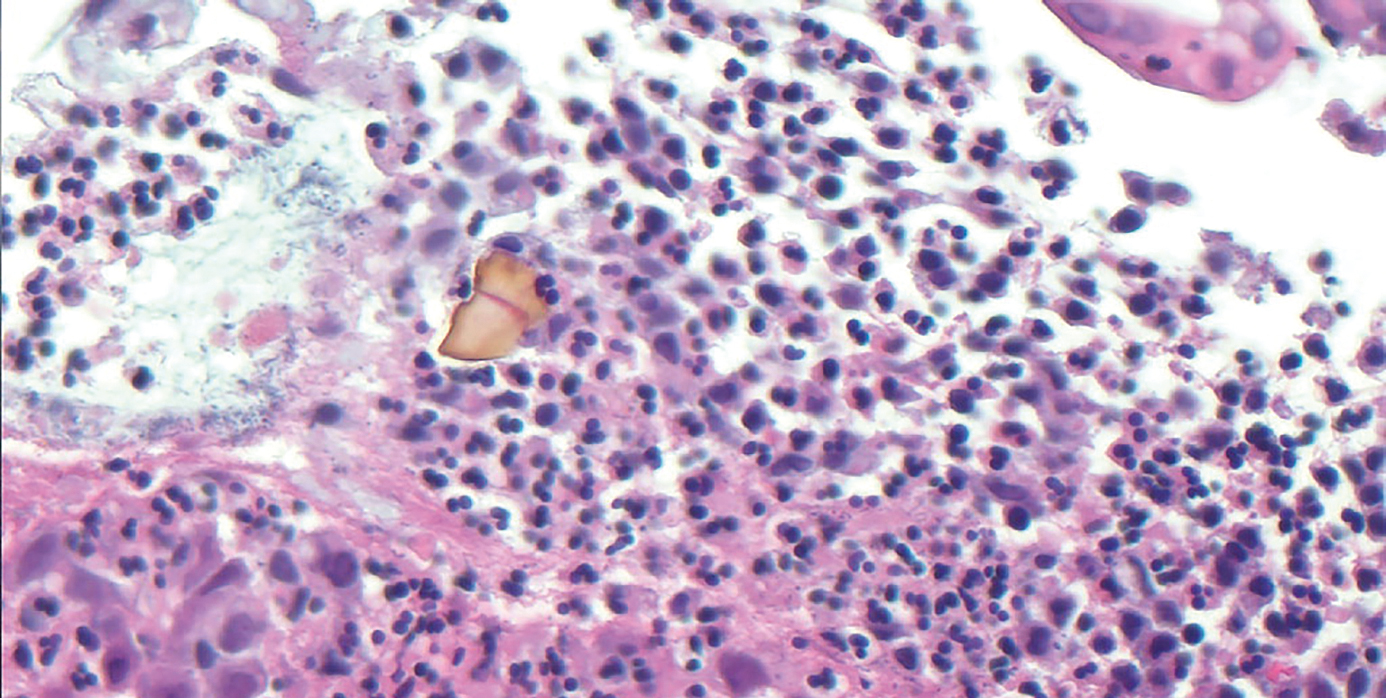

Sevelamer ist ein weit verbreitetes, nicht auf Kalzium basierendes, phosphatbindendes Mittel, das zur Senkung des Serumphosphatspiegels bei chronischer Nierenerkrankung (CKD) und Nierenerkrankung im Endstadium (end-stage renal disease, ESRD) eingesetzt wird. In der Regel ist es gut verträglich, in einzelnen Fällen kann es jedoch zu Verletzungen der Magen-Darm-Schleimhäute als Folge der Einnahme kommen.
Autoren
- Jens Dehn
Publikation
- GASTROENTEROLOGIE PRAXIS
Related Topics
Dir könnte auch gefallen
- Vom Symptom zur Diagnose
Pneumologie – Covid-19: ein Rückblick
- Altersbedingte neurokognitive Störungen
Neuroprotektive Wirkungen des Ginkgo-biloba-Extrakts
Wie Herkunft und Wohnort den CF-assoziierten Diabetes fördern
- Pankreaskarzinom
Innovative Früherkennung mit Fokus auf Liquid Biopsy und KI
- Vom Symptom zur Diagnose
Abdominalschmerz – Prostataabszess
- Asthma in der Schwangerschaft
Bis zu 40% erleiden Symptomverschlechterung während der Gravidität
- Vom Symptom zur Diagnose
Komplizierte Nierenzysten
- Schweres Asthma und CRSwNP